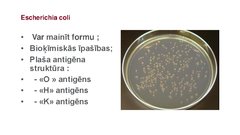
Prezentācija 'Escherichia coli mikrobioloģiskās diagnostikas principi', 4.
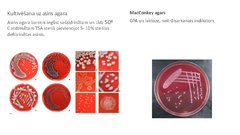
Prezentācija 'Escherichia coli mikrobioloģiskās diagnostikas principi', 10.
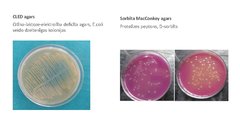
Prezentācija 'Escherichia coli mikrobioloģiskās diagnostikas principi', 11.
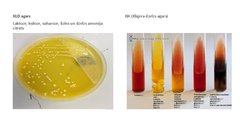
Prezentācija 'Escherichia coli mikrobioloģiskās diagnostikas principi', 12.

-
Escherichia coli mikrobioloģiskās diagnostikas principi

-
Escherichia coli mikrobioloģiskās diagnostikas principi
AugstskolaPrezentācija15 -
Kušinga sindroms
AugstskolaPrezentācija16 -
Lokālas infekcijas neonatālā periodā
AugstskolaPrezentācija13
Escherichia coli mikrobioloģiskās dia...
Faila izmērs:
3772 KB
Identifikators:
1399287